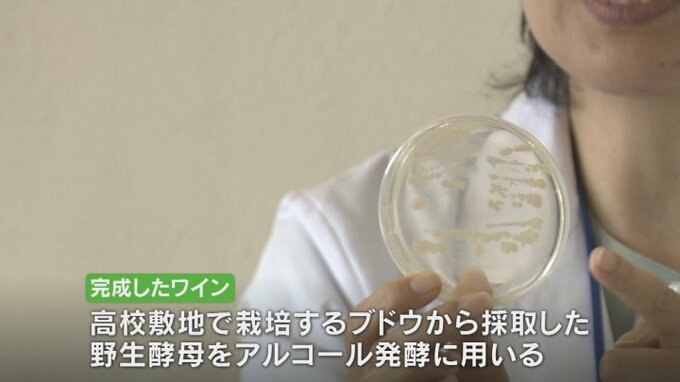

山梨県立農林高校で自然酵母を使って発酵させた特別仕込みのワインが醸造されました。7日に完成発表会が行われました。

農林高校の3年生によって作られたのは、「17ansクラージュ2023」です。
農林高校では、4年前から地場産業であるワインの醸造を学ぶ授業が行われていて、今年完成したワインがお披露目されました。

三浦正則アナウンサー:
「このワイン最大の特徴は発酵のコントロールが難しい自然由来の酵母を使用していることです」
通常、ワインの発酵には人工的に培養された酵母を使用しますが、このワインは学校の敷地で栽培するブドウから採取した野生酵母をアルコール発酵に使っています。
これによりその土地ならではの特徴のある香りや味に仕上がり、今回のワインは爽やかな香りに程よい苦味や渋みが味わえるということです。

山梨県立農林高校食品科学科3年 丸山絢花さん:
「2年生の時から作ってきたのでやっと完成できて良かった。高校生が一からつくったワインなので味わって飲んでほしい」

価格は1本750mlで2420円、8日から甲府市「リカーショップながさわ」と笛吹市の「澤田屋酒店」で販売されます。







